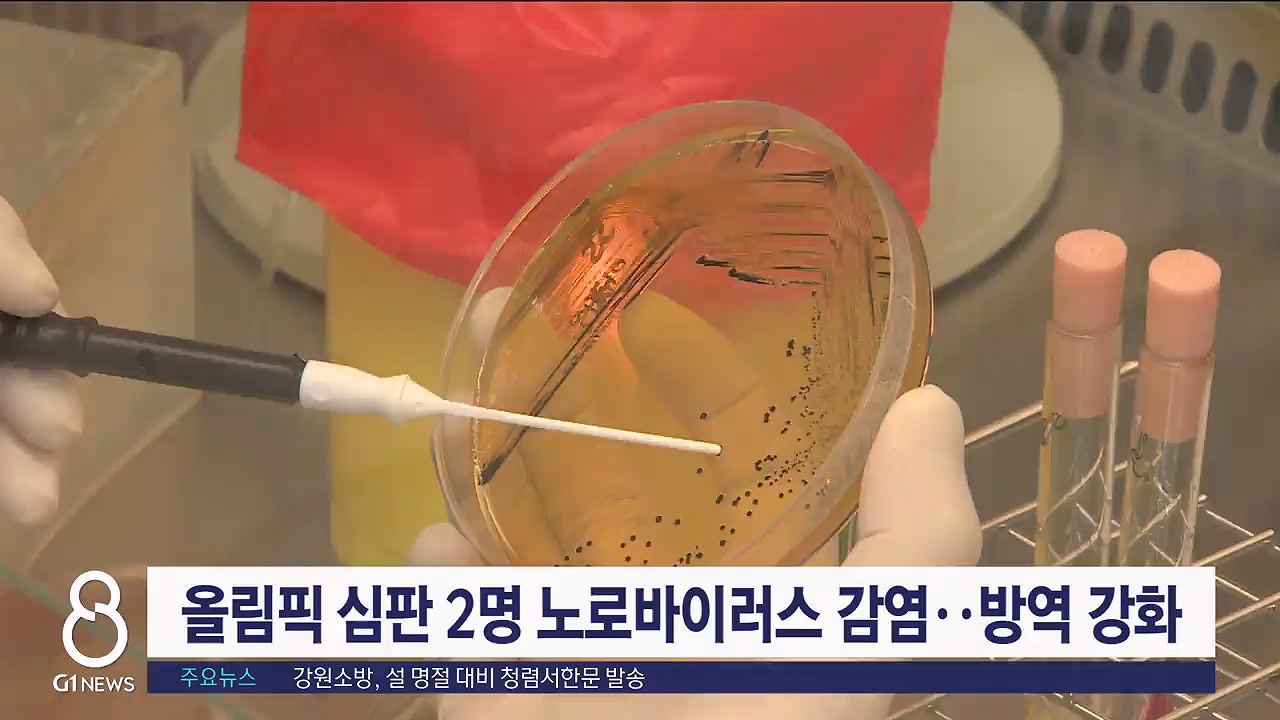

매일 저녁 8시 35분
평일 고유림주말 고유림, 신아림, 박진형
올림픽 심판 2명 노로바이러스 감염..방역 강화
2024-01-17
정창영 기자[ window@g1tv.co.kr ]
키보드 단축키 안내
2024 강원동계청소년올림픽에 참가하는 심판 2명이 노로바이러스에 감염된 것으로 최종 확인됐습니다.
도 보건환경연구원 정밀검사 결과, 의심증상자 6명 가운데 심판 2명에게서 노로바이러스가 확인됐습니다.
방역당국은 현재까지 시설 환경과 조리시설 등에서 바이러스 감염이 발견되지 않아 대회 참가 이전에 노로바이러스에 감염된 것으로 추측하고 있습니다.
식약처와 조직위는 내일까지 선수촌 식당과 식음료 취급시설을 대상으로 식중독균 신속 검사를 진행하는 등 최종 점검에 나섭니다.
도 보건환경연구원 정밀검사 결과, 의심증상자 6명 가운데 심판 2명에게서 노로바이러스가 확인됐습니다.
방역당국은 현재까지 시설 환경과 조리시설 등에서 바이러스 감염이 발견되지 않아 대회 참가 이전에 노로바이러스에 감염된 것으로 추측하고 있습니다.
식약처와 조직위는 내일까지 선수촌 식당과 식음료 취급시설을 대상으로 식중독균 신속 검사를 진행하는 등 최종 점검에 나섭니다.
정창영 기자 window@g1tv.co.kr
Copyright ⓒ G1방송. All rights reserved. 무단 전재 및 재배포 금지.